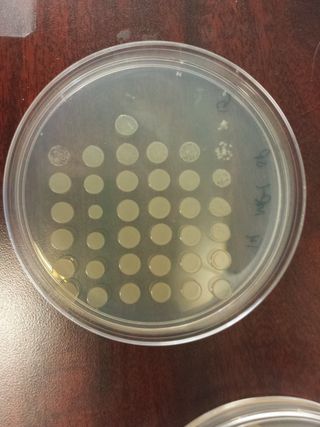

Research Investigations
The purpose of my ongoing geobiological and astrobiological research is to understand how life can thrive in extreme environments, leaving behind evidence of their former (or current) habitats. Using Earth field sites as my planetary test beds, I investigate the persistence of life "as we know it" on our own planet to biological and geological signs of life elsewhere in the solar system.
Biomarker and Biosignature Validation in Extreme Environments
Understanding how life on Earth persists within extreme environments can help us understand how life, their chemical biomarkers, and biosignatures in the mineral record can be preserved and validated on other solar system bodies.

Evaporite Mineralogy and Hypersaline Brines
At the core of my research is evaporite mineralogy and the geobiological preservation ability of life from their ancient aqueous environments. Modern lake beds on Earth are ideal testbeds for ancient/dried lakebed analyses on Mars.
Microbiological Analysis and Validation of Life
In parallel to investigating ancient biomarkers and biosignatures, it is critical to understand the source biology whose metabolic processes created the evidence we are working to quantify over geologic time.

Quantifying Habitability for Planetary Exploration
As we continue to explore Mars with planetary rovers and orbiters, the ability to associate the habitability of Mars, and eventually Europa, must take into account ancient-to-modern environmental conditions. Global (orbital) and local (rover) features must be compared to ancient fluvial settings to understand the persistence of life and the remaining evidence of former potential habitats.

Laboratory analysis of in-situ samples
Sample collection from the field and real-time analysis are critical for understanding biomass and biosignature/biomarker preservation.

Planetary Analogue Fieldwork
Our understanding from planetary rovers and orbiter data sets only go so far. It is imperative that a combined understanding regarding ancient aqueous environments tie together geobiology, sedimentology, and microbiology to understand planetary analogue environments and their relation to regions on Mars and Europa.